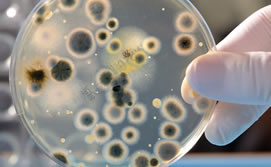
2010-07-09-dispositivo_ik4_med

The portable device is able to detect Chlamydia, the presence of the human papillomavirus (which can cause cancer of the uterus), and other Sexually Transmitted Diseases (STDs) in less than half an hour. It will be launched in India in 2012.
With an estimated population of 1,198 million inhabitants, it’s estimated that more than 82.5 million people in that country are affected by one of these pathologies. Chlamydia is especially worrisome, as it is undiagnosed in 90% of cases, transmitted by sexual contact and only affects women. Found also in Europe, Chlamydia can affect the brain, cause blindness and produce miscarriages, premature births and premature rupture of the membranes. It is also a key factor in the high degree of infant mortality and infertility.
The new diagnostic device miniaturizes a conventional laboratory within a chip. It is also highly specific, portable and easy to use, permitting the rapid identification of pathogens, genetic alterations, degenerative disease markers, etc. The system incorporates in the chip the isolation of the pathogen, breaking it down to free its genetic material, multiplying specific DNA fragments and, finally, detection. The user only has to introduce the type of fluid (saliva, blood, tears, etc.) that the device requires, according to the disease being detected.
This technological development, which does not require the infrastructure of a laboratory, carries out complex detection techniques from clinical samples, and is more efficient and profitable than other current techniques. Although there are many possible applications for the new device, to begin with the research centered upon two applications that are differentiated by the type of sample and by the pathogen being detected: the detection of Campylobacteriosis in farm animals (animal health application) and the detection of Salmonellosis in human beings (human health application). Currently adaptations are being carried out to quickly detect viruses causing respiratory system infections, and to study the efficiency of oncological treatments. Further, the device can be adapted to detect the majority of diagnosable infections using molecular biology techniques, including metabolic disorders and oncological diagnoses, which represent approximately 80% of the pathologies classified by the World Health Organization (WHO).